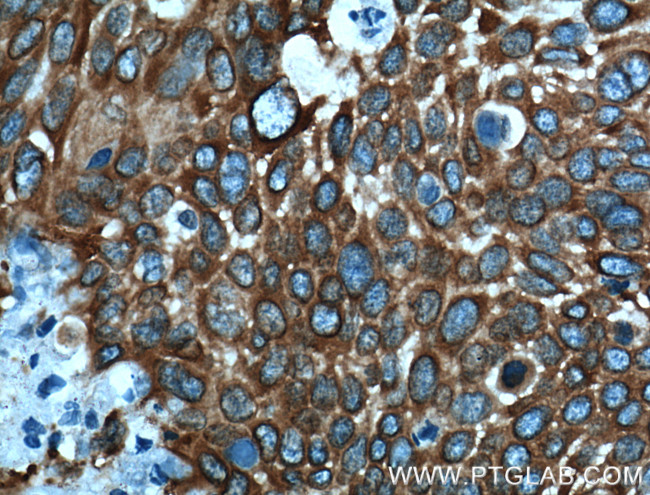
MAP4 Antibody in Immunohistochemistry (Paraffin) (IHC (P))

Search
Proteintech
MAP4 Polyclonal Antibody
{{$productOrderCtrl.translations['antibody.pdp.commerceCard.promotion.promotions']}}
{{$productOrderCtrl.translations['antibody.pdp.commerceCard.promotion.viewpromo']}}
{{$productOrderCtrl.translations['antibody.pdp.commerceCard.promotion.promocode']}}: {{promo.promoCode}} {{promo.promoTitle}} {{promo.promoDescription}}. {{$productOrderCtrl.translations['antibody.pdp.commerceCard.promotion.learnmore']}}
产品信息
11229-1-AP
种属反应
已发表种属
宿主/亚型
分类
类型
抗原
偶联物
形式
浓度
规格
纯化类型
保存液
内含物
保存条件
运输条件
产品详细信息
Immunogen sequence: KSTQTVAKT TTAAAVASTG PSSRSPSTLL PKKPTAIKTE GKPAEVKKMT AKSVPADLSR PKSTSTSSMK KTTTLSGTAP AAGVVPSRVK ATPMPSRPST TPFIDKKPTS AKPSSTTPRL SRLATNTSAP DLKNVRSKVG STENIKHQPG GGRAKVEKKT EAAATTRKPE SNAVTKTAGP IASAQKQPAG KVQIVSKKVS YSHIQSKCGS KDNIKHVPGG GNVQIQNKKV DISKVSSKCG SKANIKHKPG GGDVKIESQK LNFKEKAQAK VGSLDNVGHL PAGGAVKTEG GGSEAPLCPG PPAGEEPAIS EAAPEAGAPT SASGLNGHPT LSGGGDQREA QTLDSQIQET SI (629-979 aa encoded by BC012794)
靶标信息
The protein encoded by this gene is a major non-neuronal microtubule-associated protein. This protein contains a domain similar to the microtubule-binding domains of neuronal microtubule-associated protein (MAP2) and microtubule-associated protein tau (MAPT/TAU). This protein promotes microtubule assembly, and has been shown to counteract destabilization of interphase microtubule catastrophe promotion. Cyclin B was found to interact with this protein, which targets cell division cycle 2 (CDC2) kinase to microtubules. The phosphorylation of this protein affects microtubule properties and cell cycle progression. Multiple transcript variants encoding different isoforms have been found for this gene. [provided by RefSeq].
仅用于科研。不用于诊断过程。未经明确授权不得转售。
生物信息学
蛋白别名: MAP 4; MAP-4; Microtubule-associated protein 4; unnamed protein product
基因别名: AA407148; MAP-4; MAP4; Mtap-4; Mtap4
UniProt ID: (Human) P27816, (Mouse) P27546, (Rat) Q5M7W5
Entrez Gene ID: (Human) 4134, (Mouse) 17758, (Rat) 367171